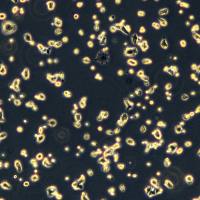
NCI-H520细胞敲除hGALNT14基因细胞株

相关产品推荐更多 >
万千商家帮你免费找货
0 人在求购买到急需产品
- 详细信息
- 技术资料
细胞名称:NIH-3T3细胞敲除mPtbp1基因细胞株
细胞简称:NIH-3T3 KO mPtbp1 Cell Line
产品货号:CTCC-KO-1053
基因名称:mPtbp1
基因ID:19205
转导方法:蛋白法
细胞类型:纯合子
细胞鉴定:PCR,测序
种属来源:小鼠
组织来源:胚胎
疾病特征:/
细胞形态:成纤维细胞样
生长特性:贴壁生长
风险提示:丁香通仅作为第三方平台,为商家信息发布提供平台空间。用户咨询产品时请注意保护个人信息及财产安全,合理判断,谨慎选购商品,商家和用户对交易行为负责。对于医疗器械类产品,请先查证核实企业经营资质和医疗器械产品注册证情况。
 技术资料
技术资料暂无技术资料 索取技术资料
NIH-3T3细胞敲除mPtbp1基因细胞株
询价